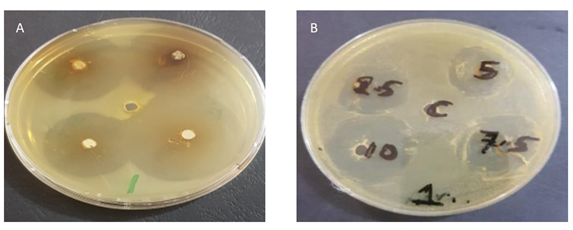
A/ Results of the antibiotic oxytetracycline against Aeromonas sobria  and B/ antibiotic activity of Aeromonas sobria against lemongrass alcoholic methanolic extract (replace it).

About the Journal
The Iraqi Journal of Aquaculture (IJAQ) is a reputable scientific journal that provides open access to its publications. Since 2004, the Marine Science Center at the University of Basrah, Iraq, has been publishing this journal biannually. IJAQ adheres to the Creative Commons Attribution 4.0 International (CC-BY 4.0) licensing agreement, ensuring that its published materials are available to a broad audience.
To maintain the integrity of the journal and prevent plagiarism, IJAQ employs the Turnitin program, which evaluates the originality of submitted manuscripts. Additionally, the journal employs a double-blind peer-review system to ensure the quality of published works.
IJAQ welcomes original research articles, review papers, and case reports in fields such as fisheries, aquaculture, aquatic management, wetlands, lakes, water pollution, and other related areas.
Authors submitting their work to IJAQ are required to pay a 100.000 Iraqi dinar fee upon acceptance of their manuscript.
Payment is made directly at the editorial office or via electronic payment:
Zain Cash: +964(0)7731361611
Publishing for researchers from outside Iraq is free
It is essential to note that IJAQ does not receive any financial support from governmental or non-governmental organizations, emphasizing the journal's independence and autonomy.